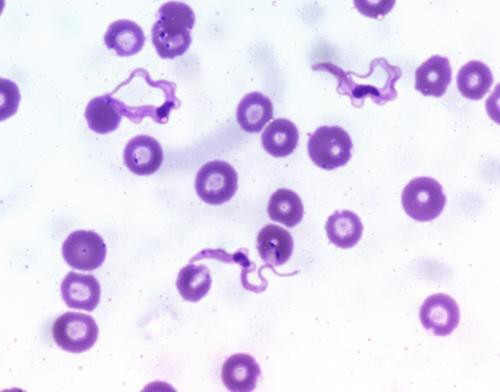
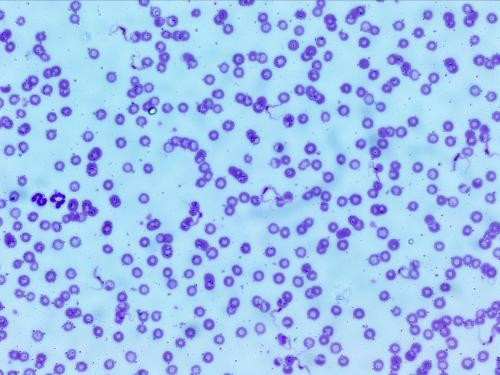

The Journal of Advances in Parasitology
Case Report
J. Adv. Parasitol. 2 (3): 65 - 68
Figure 1
Thin PBS smear showing centrally located nucleus with a sub terminal kinetoplast at sharp posterior end and large undulating membrane with free flagellum (Leishman stain, 1000X)
Figure 2
Thin smear of the culture on NNN media showing plenty of long, slender, flagellated, (15-34 μm) dividing forms of trypanosomes (Leishman stain, 1000X)
Figure 3
Binary division stage of trypanosome